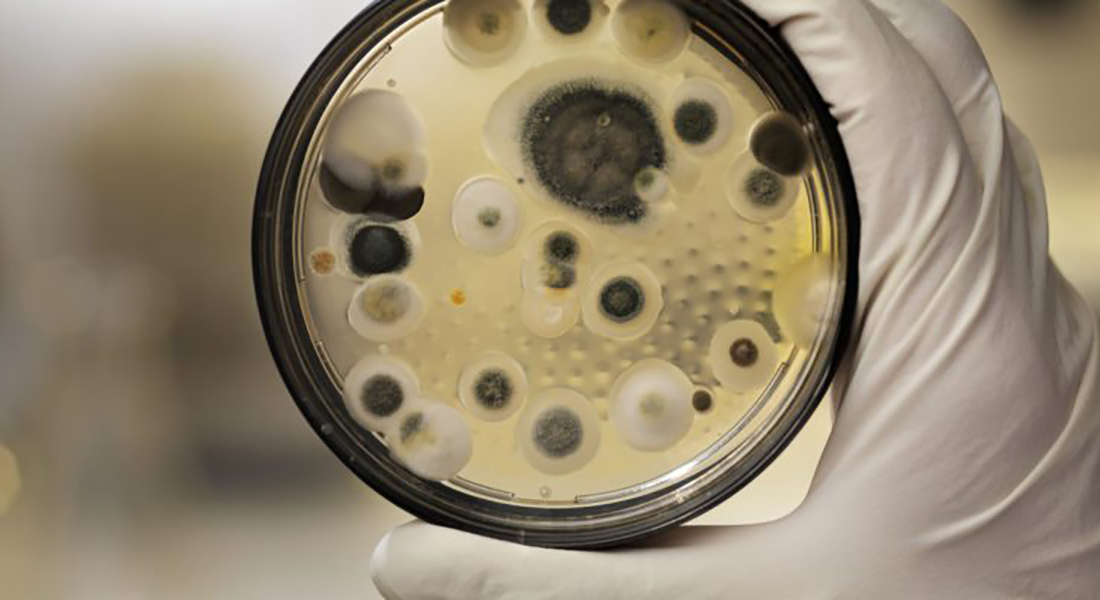
black mold

17 Jun NJDEP Imposes More Stringent Standard for Lead
On May 6, 2024, the New Jersey Department of Environmental Protection (NJDEP) reduced the residential soil remediation standard for the ingestion-dermal exposure pathway for lead from 400 mg/kg to 200 mg/kg. Basis for the Change to NJDEP Lead Standard This updated standard reflects revisions that the United...